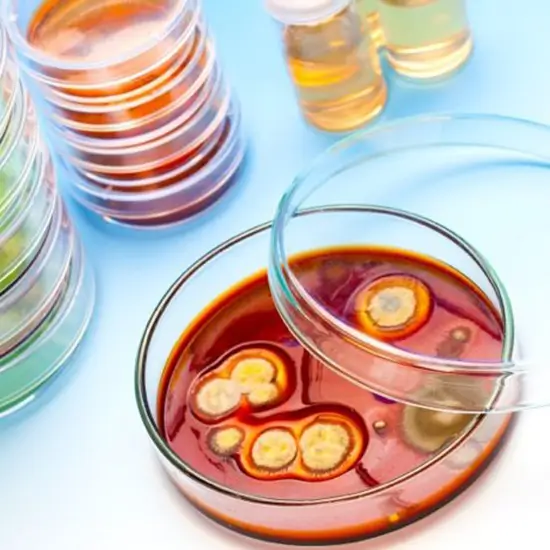

Book Culture Aerobic Vaginal Swab Appointment Online Near me at the best price in Delhi/NCR from Ganesh Diagnostic. NABL & NABH Accredited Diagnostic centre and Pathology lab in Delhi offering a wide range of Radiology & Pathology tests. Get Free Ambulance & Free Home Sample collection. 24X7 Hour Open. Call Now at 011-47-444-444 to Book your Culture Aerobic Vaginal Swab at 50% Discount.
Bacteria are microorganisms that have only one cell. They are present everywhere around us; in oceans, soil, skin, stomach. Some bacteria play an important role in overall wellbeing of our body but there are some harmful bacteria as well that are the causes of a lot of diseases and infection.
Culture aerobic vaginal swab test is done to identify an aerobic bacterium that causes vaginal infections and this test is also helpful in finding the right diagnose for the infection. This test is suggested to young girls and women that are prone to UTI’s. Diabetic women are prone to get these infections more than a woman who does not have diabetes.
If having following symptoms
• Feeling discomfort and pain while having sexual intercourse
• Swelling in the vagina
• Discharge from vagina with foul smell
• Burning sensation at the time of urination
• Discuss all your medicines and allergies with your gynaecologist before this test.
• Your doctor will give you all the instruction according to your condition.
• Patients are advised to not do vaginal douching 24 hours prior the test.
• It is also suggested to avoid vaginal intercourse 24 hours prior to the test for the reliable results.
The cost of the test varies from INR 800 to INR 1200 according to your chosen laboratory.
| Test Type | Culture Aerobic Vaginal Swab |
| Includes | Culture Aerobic Vaginal Swab Test (Pathology Test) |
| Preparation | |
| Reporting | Within 24 hours* |
| Test Price |
₹ 700
|

Early check ups are always better than delayed ones. Safety, precaution & care is depicted from the several health checkups. Here, we present simple & comprehensive health packages for any kind of testing to ensure the early prescribed treatment to safeguard your health.